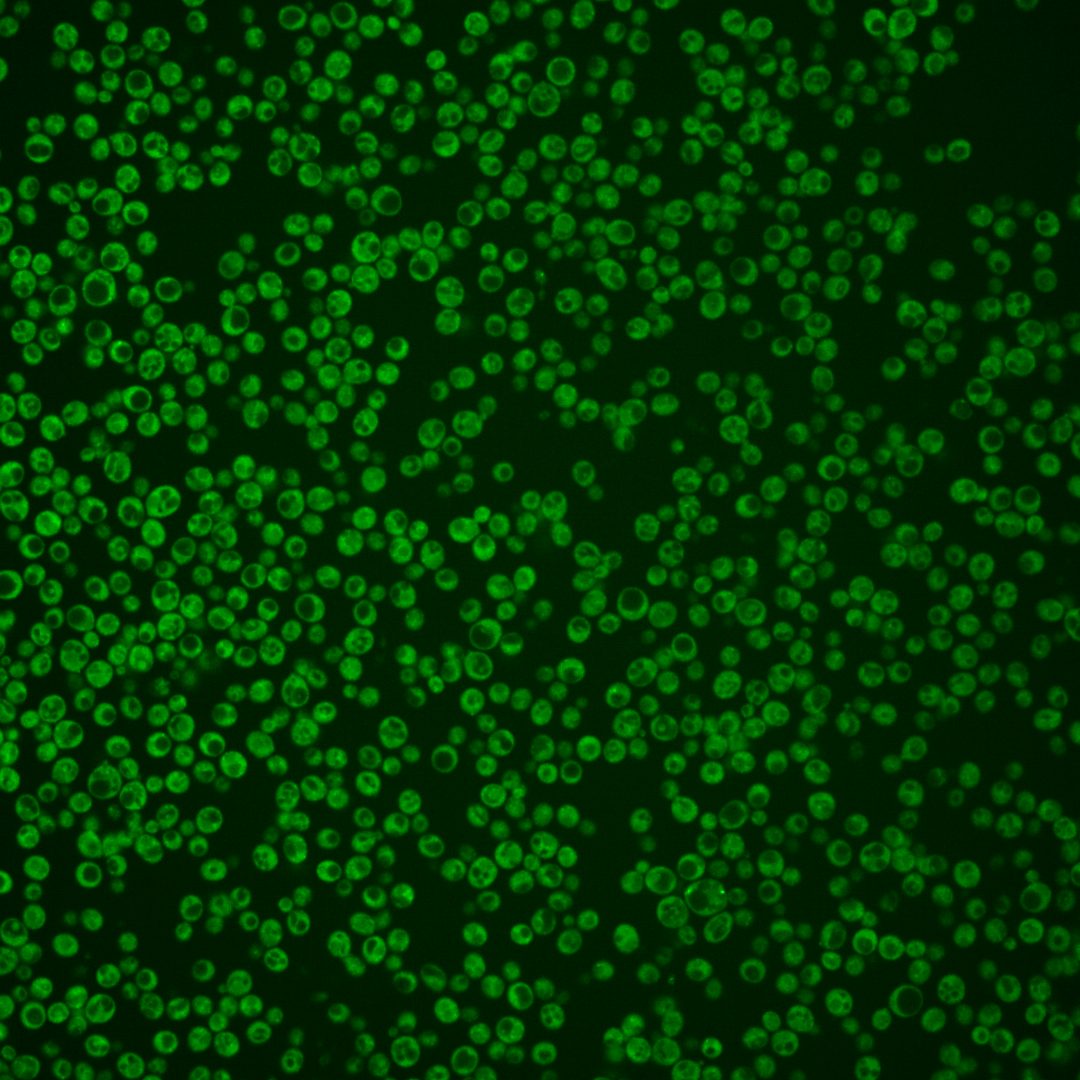
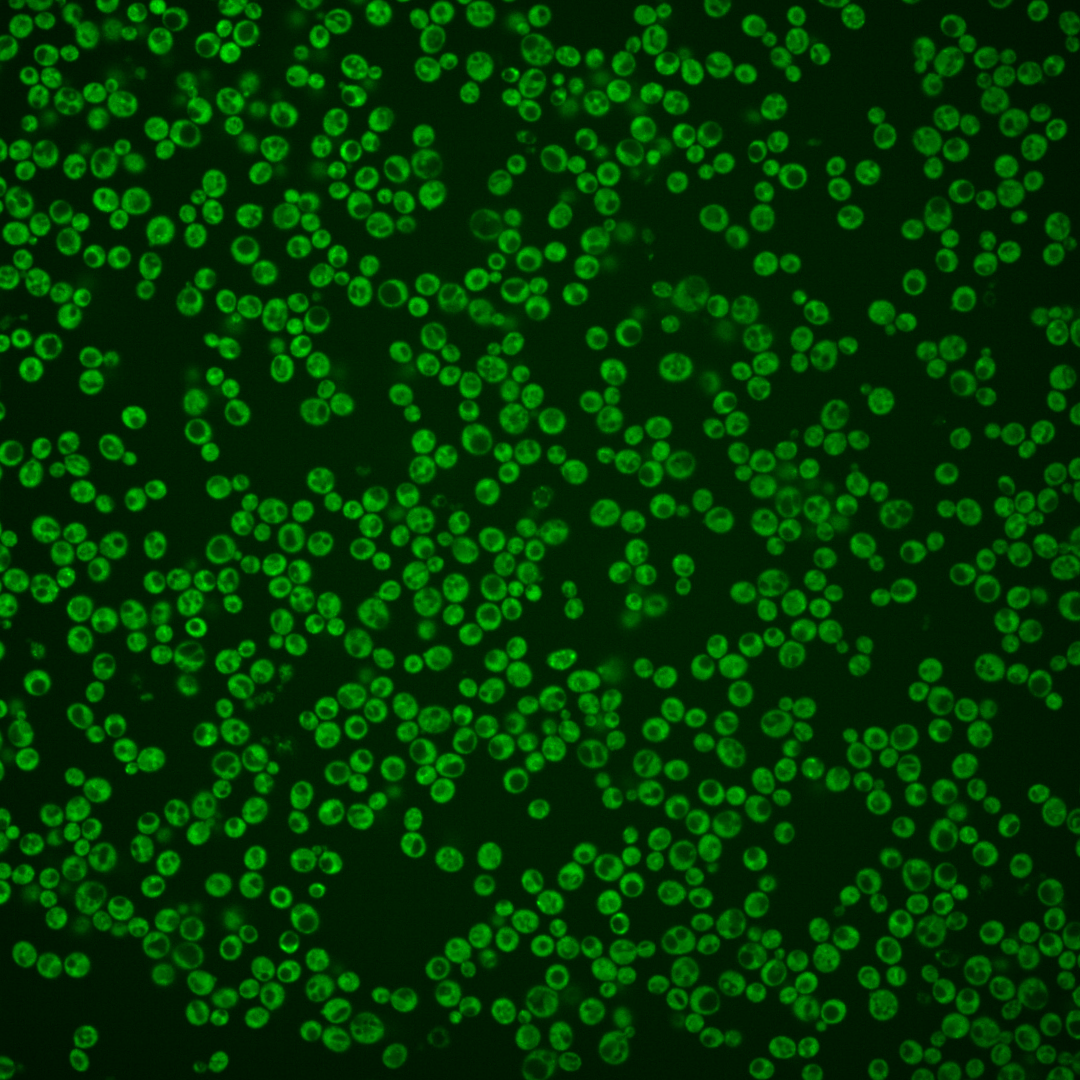
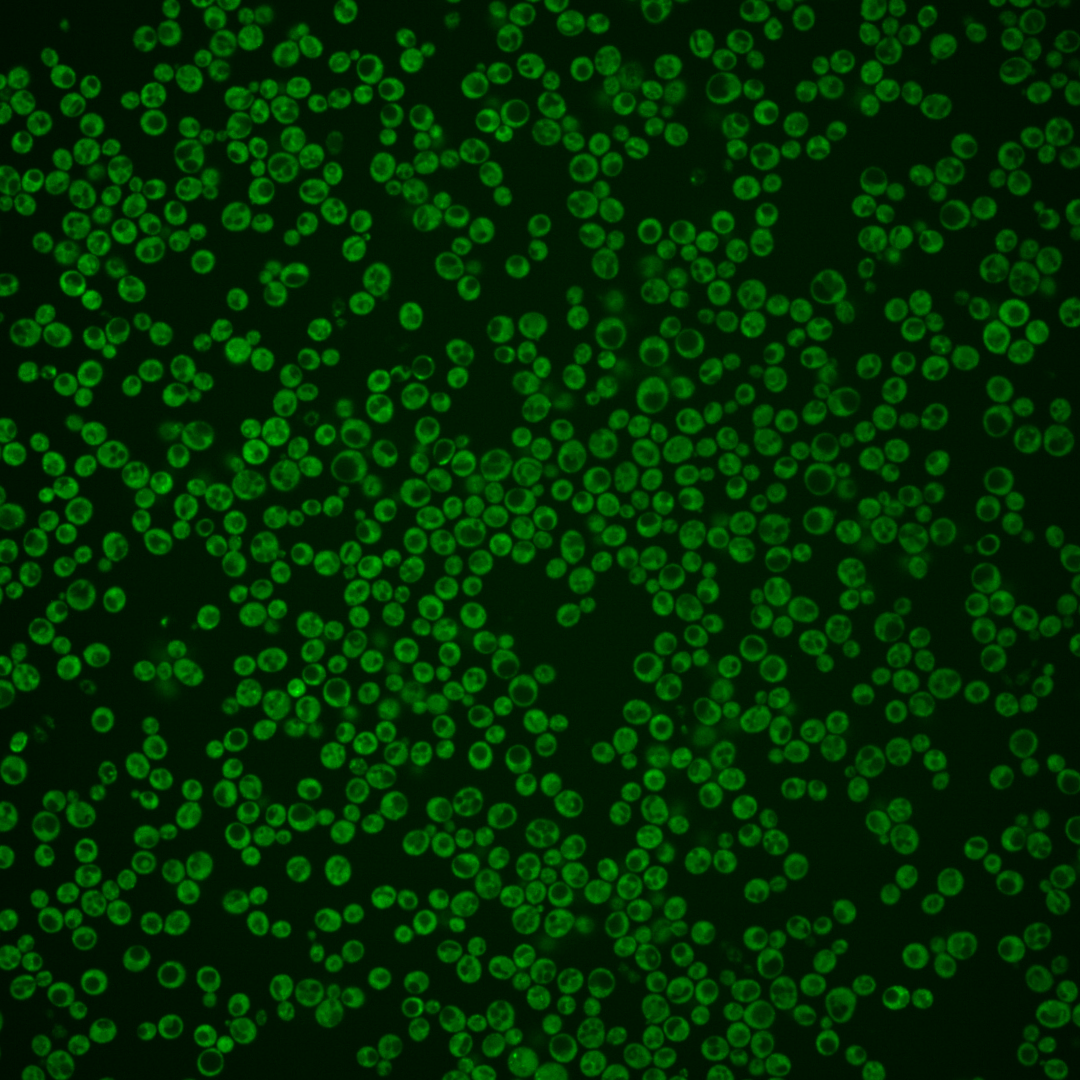
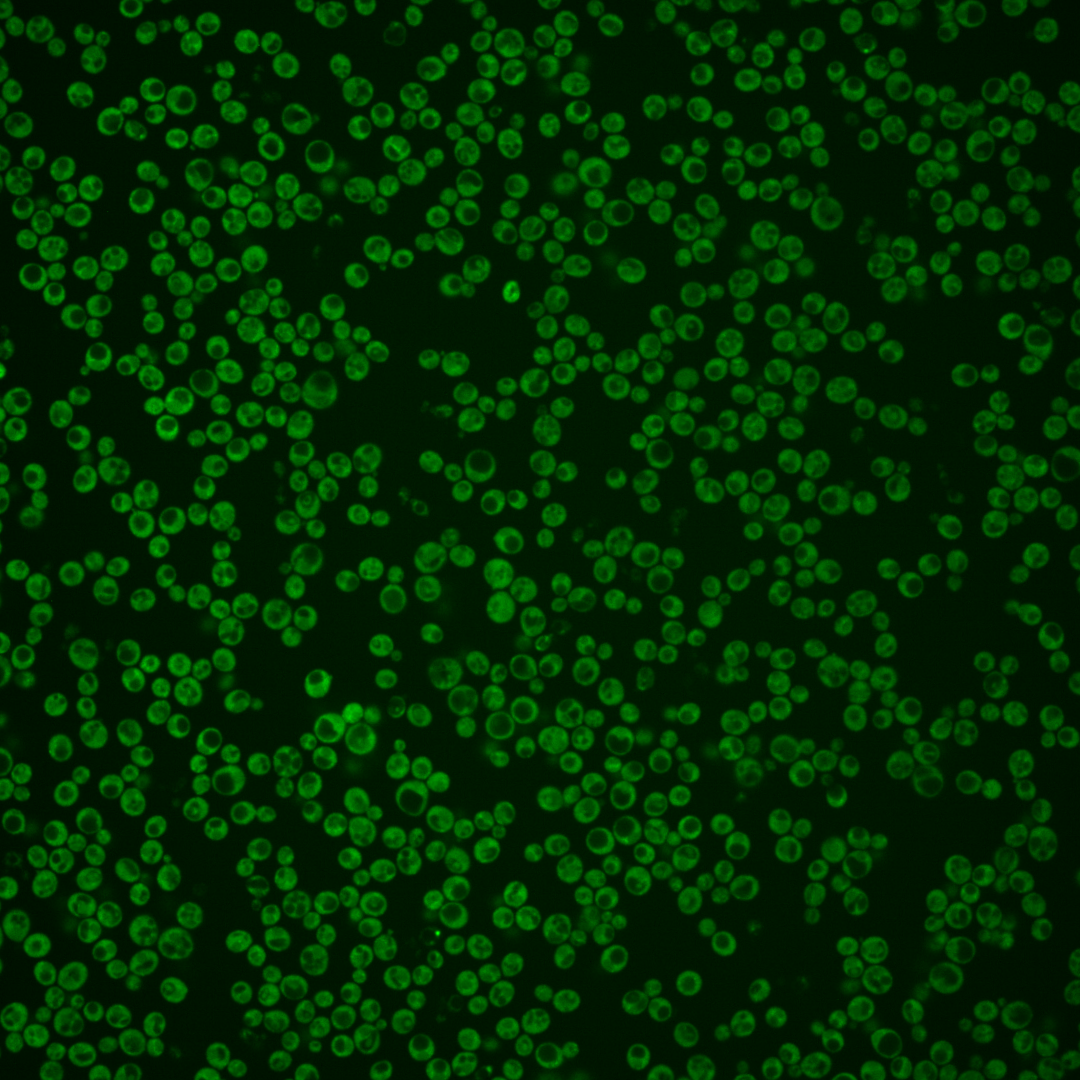
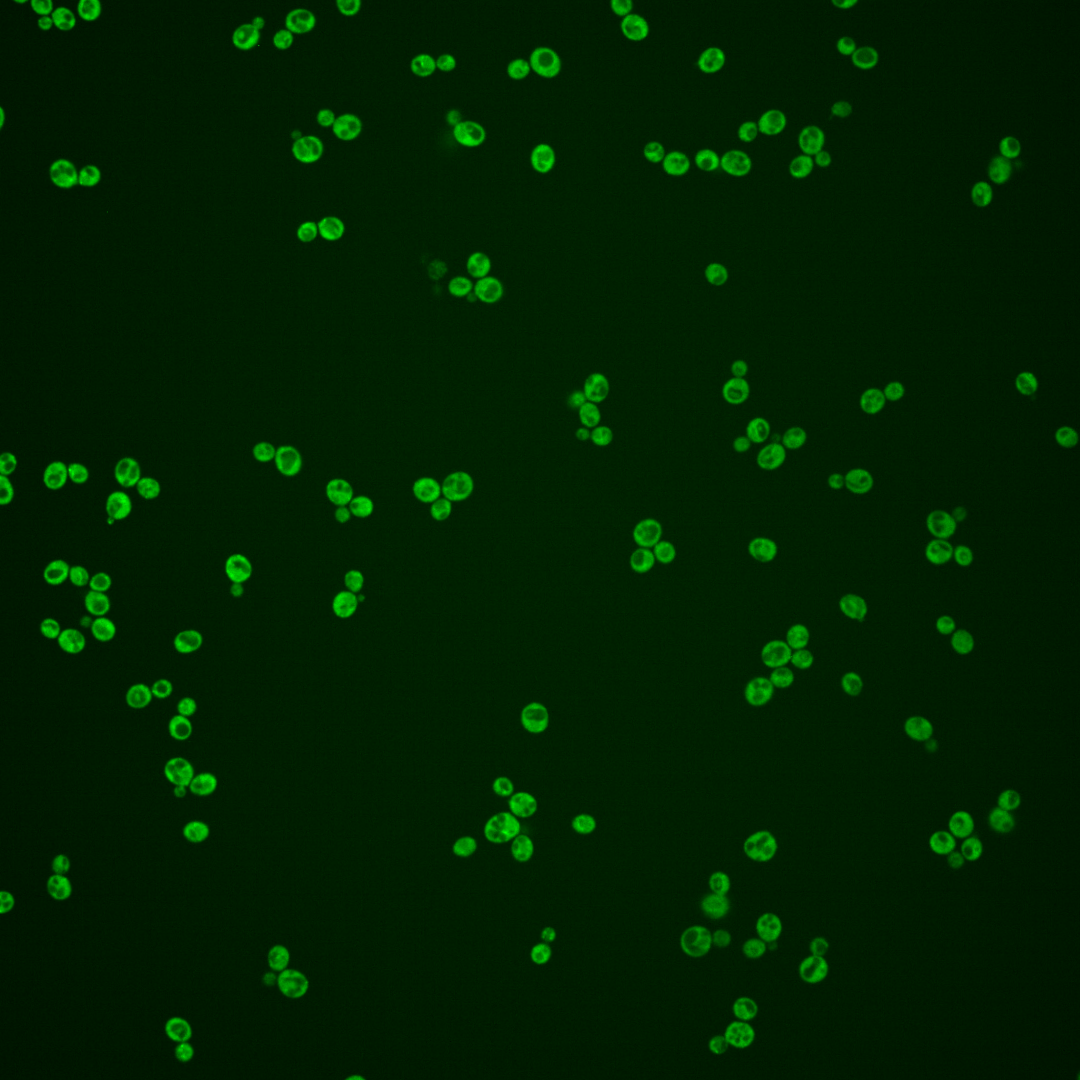
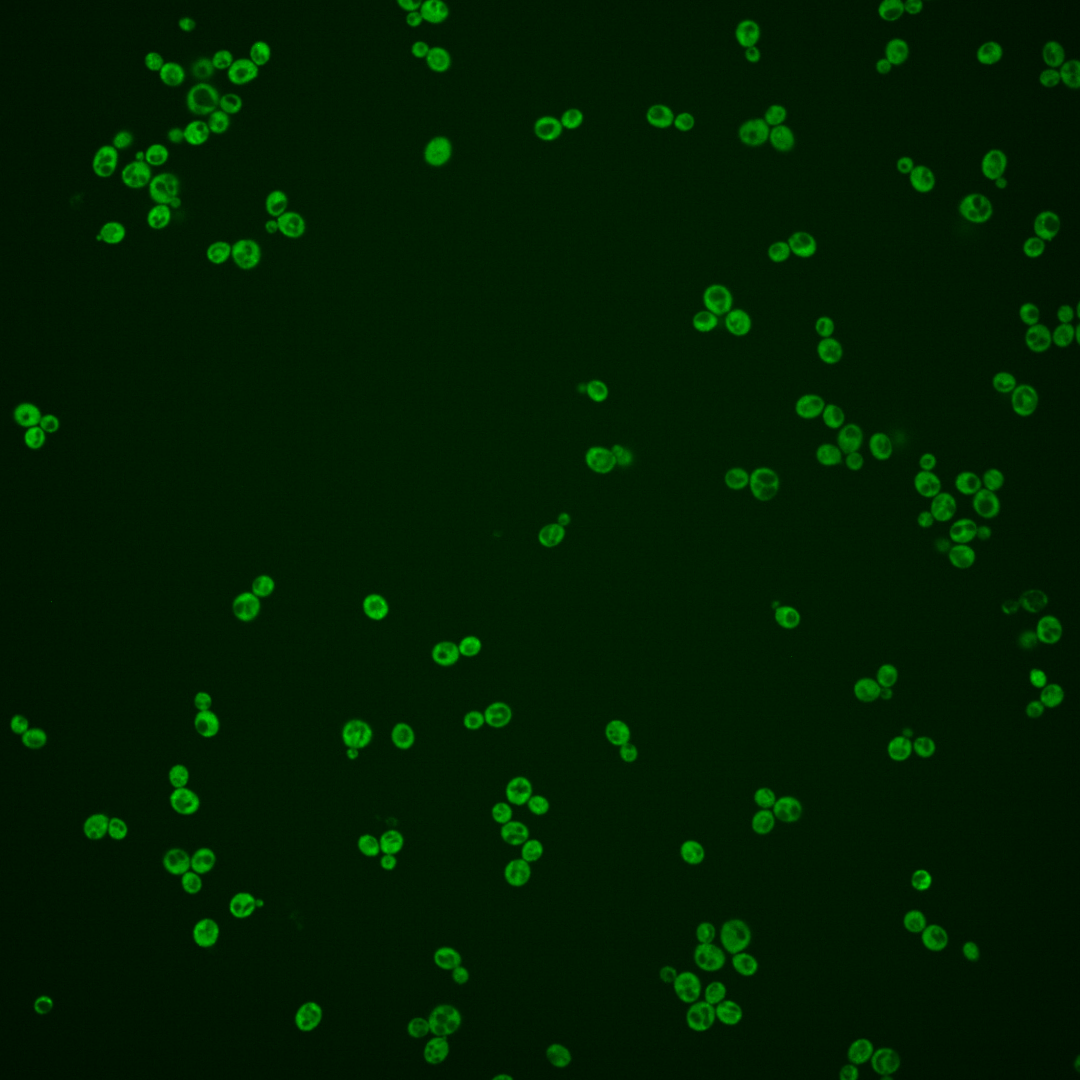
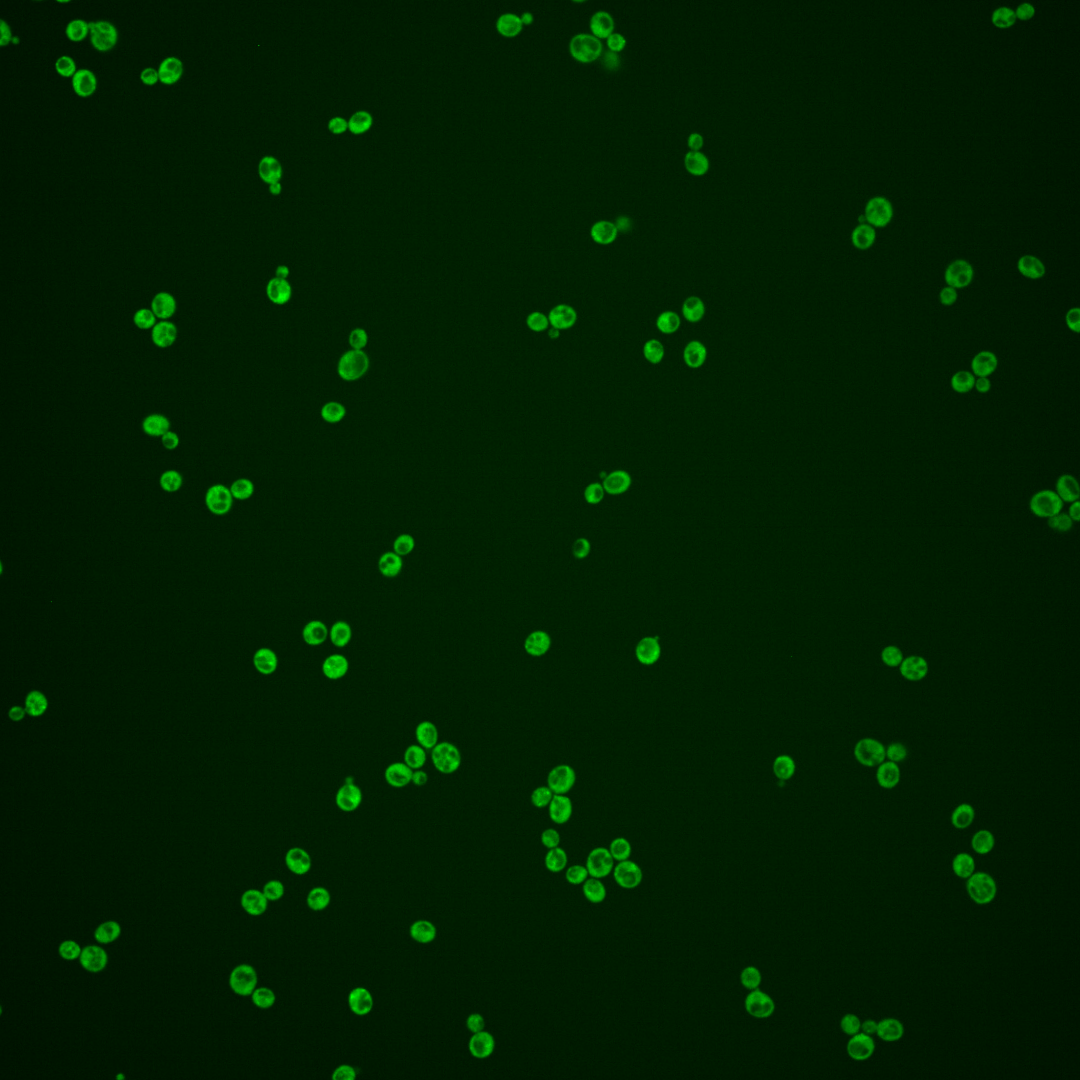
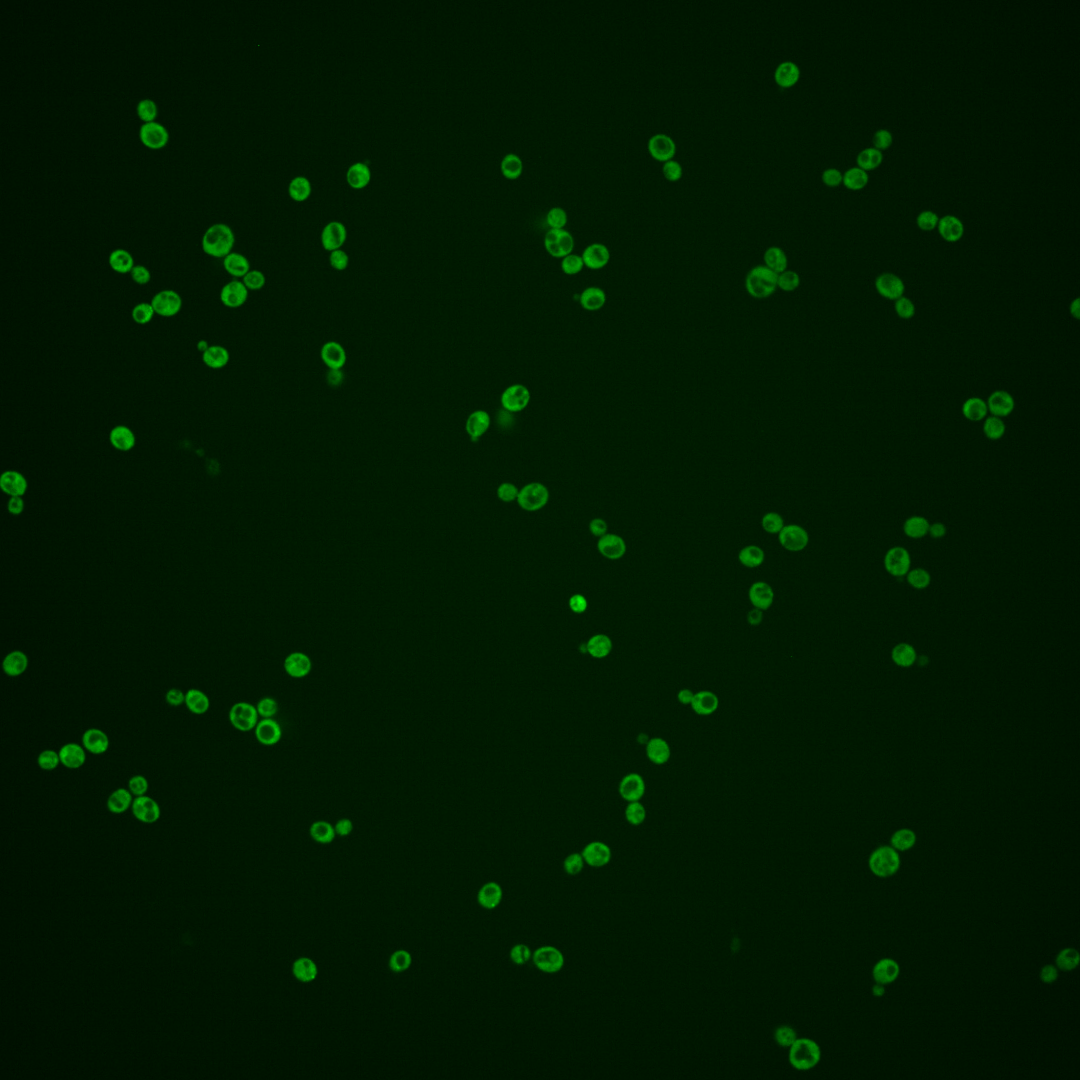

| Standard name | |
|---|---|
| Human Ortholog | |
| Description | Deadenylation-dependent mRNA-decapping factor; also required for faithful chromosome transmission, maintenance of rDNA locus stability, and protection of mRNA 3'-UTRs from trimming; associated with topoisomerase II; binds to mRNAs under glucose starvation, most often in the 3' UTR; functionally linked to Pab1p; forms cytoplasmic foci upon DNA replication stress; phosphorylation by PKA inhibits P body foci formation |
Micrographs




















































































Sub-cellular Localization
Yeast GFP Assignment
Protein Abundance
Localization Change
External localization resources
| ensLOC | DeepLoc | |||||||||||||||||||||||
|---|---|---|---|---|---|---|---|---|---|---|---|---|---|---|---|---|---|---|---|---|---|---|---|---|
| Localization | WT1 | WT2 | WT3 | RAP60 | RAP140 | RAP220 | RAP300 | RAP380 | RAP460 | RAP540 | RAP620 | RAP700 | HU80 | HU120 | HU160 | rpd3Δ_1 | rpd3Δ_2 | rpd3Δ_3 | WT1 | WT2 | WT3 | AF100 | AF140 | AF180 |
| Cortical Patches | 0 | 0 | 2 | 2 | 3 | 5 | 9 | 15 | 13 | – | 8 | 15 | 6 | 24 | 19 | 0 | 4 | 3 | 0 | 0 | 0 | 0 | 0 | 0 |
| Bud | 0 | 2 | 4 | 3 | 6 | 11 | 9 | 10 | 6 | – | 6 | 3 | 2 | 12 | 21 | 0 | 0 | 1 | 0 | 2 | 0 | 0 | 0 | 0 |
| Bud Neck | 0 | 0 | 0 | 0 | 0 | 0 | 0 | 0 | 0 | – | 0 | 0 | 0 | 0 | 0 | 0 | 0 | 0 | 0 | 0 | 2 | 0 | 0 | 0 |
| Bud Site | 0 | 0 | 0 | 0 | 0 | 0 | 1 | 0 | 0 | – | 0 | 0 | 0 | 1 | 0 | 0 | 0 | 0 | – | – | – | – | – | – |
| Cell Periphery | 2 | 3 | 10 | 10 | 11 | 11 | 8 | 6 | 5 | – | 9 | 10 | 2 | 4 | 4 | 24 | 21 | 42 | 0 | 0 | 0 | 0 | 0 | 0 |
| Cytoplasm | 143 | 198 | 209 | 196 | 233 | 165 | 230 | 203 | 112 | – | 105 | 107 | 82 | 120 | 114 | 299 | 301 | 259 | 143 | 218 | 213 | 112 | 146 | 167 |
| Endoplasmic Reticulum | 4 | 15 | 2 | 0 | 10 | 7 | 14 | 4 | 11 | – | 31 | 19 | 19 | 14 | 19 | 15 | 5 | 4 | 10 | 7 | 8 | 33 | 40 | 42 |
| Endosome | 0 | 0 | 2 | 2 | 2 | 6 | 8 | 16 | 2 | – | 1 | 2 | 1 | 24 | 50 | 0 | 0 | 0 | 0 | 0 | 1 | 1 | 1 | 0 |
| Golgi | 0 | 0 | 0 | 0 | 2 | 0 | 0 | 2 | 0 | – | 0 | 2 | 6 | 31 | 38 | 4 | 2 | 4 | 0 | 1 | 0 | 0 | 1 | 1 |
| Mitochondria | 1 | 7 | 6 | 26 | 24 | 62 | 121 | 91 | 111 | – | 130 | 92 | 8 | 9 | 17 | 4 | 3 | 6 | 2 | 0 | 6 | 2 | 5 | 3 |
| Nucleus | 1 | 0 | 0 | 2 | 1 | 0 | 3 | 3 | 1 | – | 0 | 1 | 0 | 0 | 0 | 2 | 3 | 2 | 0 | 1 | 1 | 0 | 0 | 0 |
| Nuclear Periphery | 1 | 0 | 0 | 0 | 0 | 0 | 0 | 1 | 1 | – | 0 | 0 | 1 | 0 | 0 | 0 | 0 | 0 | 0 | 0 | 0 | 0 | 0 | 0 |
| Nucleolus | 0 | 0 | 0 | 1 | 0 | 0 | 0 | 0 | 0 | – | 0 | 0 | 0 | 0 | 1 | 1 | 1 | 0 | 0 | 0 | 0 | 0 | 1 | 0 |
| Peroxisomes | 0 | 0 | 0 | 0 | 0 | 0 | 0 | 0 | 0 | – | 0 | 0 | 0 | 2 | 12 | 0 | 0 | 0 | 0 | 0 | 0 | 0 | 0 | 0 |
| SpindlePole | 0 | 0 | 0 | 0 | 0 | 0 | 0 | 0 | 1 | – | 0 | 0 | 0 | 3 | 9 | 0 | 0 | 0 | 0 | 0 | 0 | 0 | 0 | 0 |
| Vac/Vac Membrane | 2 | 1 | 18 | 8 | 20 | 27 | 47 | 102 | 32 | – | 14 | 36 | 0 | 2 | 3 | 8 | 17 | 5 | 3 | 7 | 9 | 4 | 7 | 9 |
| Unique Cell Count | 151 | 215 | 228 | 219 | 282 | 250 | 376 | 385 | 231 | 244 | 239 | 114 | 205 | 248 | 329 | 332 | 300 | 163 | 244 | 247 | 158 | 207 | 228 | |
| Labelled Cell Count | 154 | 226 | 253 | 250 | 312 | 294 | 450 | 453 | 295 | 304 | 287 | 127 | 246 | 307 | 357 | 357 | 326 | 163 | 244 | 247 | 158 | 207 | 228 | |
Yeast GFP Assignment
Protein Abundance
| Screen | WT1 | WT2 | WT3 | RAP60 | RAP140 | RAP220 | RAP300 | RAP380 | RAP460 | RAP540 | RAP620 | RAP700 | HU80 | HU120 | HU160 | rpd3Δ_1 | rpd3Δ_2 | rpd3Δ_3 | AF100 | AF140 | AF180 |
|---|---|---|---|---|---|---|---|---|---|---|---|---|---|---|---|---|---|---|---|---|---|
| Mean Cell GFP Intensity (1e-4) | 11.0 | 11.7 | 9.5 | 8.8 | 9.5 | 7.8 | 7.8 | 8.3 | 7.3 | – | 7.0 | 7.5 | 10.8 | 11.4 | 11.7 | 16.4 | 15.9 | 16.2 | 10.0 | 10.1 | 10.7 |
| Std Deviation (1e-4) | 1.5 | 2.4 | 1.3 | 1.0 | 1.2 | 1.2 | 1.3 | 1.3 | 1.3 | – | 1.4 | 1.4 | 1.8 | 1.4 | 1.6 | 2.9 | 2.9 | 2.8 | 1.4 | 1.5 | 1.4 |
| Intensity Change (Log2) | – | – | – | -0.11 | -0.01 | -0.3 | -0.28 | -0.2 | -0.38 | – | -0.45 | -0.35 | 0.18 | 0.26 | 0.29 | 0.78 | 0.74 | 0.77 | 0.07 | 0.08 | 0.16 |
Localization Change
| Localization | RAP60 | RAP140 | RAP220 | RAP300 | RAP380 | RAP460 | RAP540 | RAP620 | RAP700 | HU80 | HU120 | HU160 | rpd3Δ_1 | rpd3Δ_2 | rpd3Δ_3 |
|---|---|---|---|---|---|---|---|---|---|---|---|---|---|---|---|
| Cortical Patches | 0 | 0 | 0 | 0 | 2.2 | 2.9 | – | 0 | 3.1 | 0 | 4.7 | 3.6 | 0 | 0 | 0 |
| Bud | 0 | 0 | 1.7 | 0 | 0.7 | 0 | – | 0 | 0 | 0 | 2.3 | 3.3 | 0 | 0 | 0 |
| Bud Neck | 0 | 0 | 0 | 0 | 0 | 0 | – | 0 | 0 | 0 | 0 | 0 | 0 | 0 | 0 |
| Bud Site | 0 | 0 | 0 | 0 | 0 | 0 | – | 0 | 0 | 0 | 0 | 0 | 0 | 0 | 0 |
| Cell Periphery | 0.1 | -0.3 | 0 | -1.6 | -2.1 | -1.3 | – | -0.4 | -0.1 | 0 | -1.4 | -1.8 | 1.4 | 1.0 | 3.7 |
| Cytoplasm | -0.8 | -3.0 | -6.8 | -8.2 | -9.9 | -10.1 | – | -11.2 | -10.8 | -4.8 | -8.1 | -10.7 | -0.3 | -0.4 | -1.9 |
| Endoplasmic Reticulum | 0 | 2.0 | 0 | 2.1 | 0 | 2.5 | – | 5.0 | 3.7 | 5.7 | 3.3 | 3.6 | 2.5 | 0 | 0 |
| Endosome | 0 | 0 | 0 | 0 | 2.3 | 0 | – | 0 | 0 | 0 | 4.7 | 6.7 | 0 | 0 | 0 |
| Golgi | 0 | 0 | 0 | 0 | 0 | 0 | – | 0 | 0 | 0 | 6.1 | 6.2 | 0 | 0 | 0 |
| Mitochondria | 3.8 | 2.8 | 6.9 | 8.6 | 6.9 | 11.2 | – | 12.1 | 9.5 | 0 | 1.0 | 2.1 | 0 | 0 | -0.5 |
| Nucleus | 0 | 0 | 0 | 0 | 0 | 0 | – | 0 | 0 | 0 | 0 | 0 | 0 | 0 | 0 |
| Nuclear Periphery | 0 | 0 | 0 | 0 | 0 | 0 | – | 0 | 0 | 0 | 0 | 0 | 0 | 0 | 0 |
| Nucleolus | 0 | 0 | 0 | 0 | 0 | 0 | – | 0 | 0 | 0 | 0 | 0 | 0 | 0 | 0 |
| Peroxisomes | 0 | 0 | 0 | 0 | 0 | 0 | – | 0 | 0 | 0 | 0 | 3.4 | 0 | 0 | 0 |
| SpindlePole | 0 | 0 | 0 | 0 | 0 | 0 | – | 0 | 0 | 0 | 0 | 0 | 0 | 0 | 0 |
| Vacuole | -1.9 | -0.3 | 1.1 | 1.8 | 5.6 | 2.0 | – | -0.9 | 2.4 | -3.1 | -3.4 | -3.5 | -3.0 | -1.3 | -3.5 |
External localization resources
Images






























Protein Concentration and Protein Localization Data
| R1 | R2 | R3 | ||||||||||||||||
|---|---|---|---|---|---|---|---|---|---|---|---|---|---|---|---|---|---|---|
| G1 Pre-START | G1 Post-START | S/G2 | Metaphase | Anaphase | Telophase | G1 Pre-START | G1 Post-START | S/G2 | Metaphase | Anaphase | Telophase | G1 Pre-START | G1 Post-START | S/G2 | Metaphase | Anaphase | Telophase | |
| Concentration | 7.8289 | 11.4378 | 10.1369 | 8.5425 | 8.1503 | 10.0127 | 7.4177 | 10.5373 | 9.4806 | 8.946 | 8.2846 | 9.1946 | 6.3507 | 9.3889 | 8.5362 | 7.371 | 7.1834 | 8.2778 |
| Actin | 0.0153 | 0.002 | 0.0022 | 0.0017 | 0.0106 | 0.0013 | 0.0185 | 0.0011 | 0.0038 | 0.0046 | 0.0063 | 0.006 | 0.0281 | 0.0017 | 0.0062 | 0.0386 | 0.0307 | 0.0016 |
| Bud | 0.0008 | 0.001 | 0.0011 | 0.0015 | 0.001 | 0.0007 | 0.0011 | 0.0008 | 0.0012 | 0.001 | 0.0019 | 0.0005 | 0.0009 | 0.0006 | 0.0009 | 0.0004 | 0.0049 | 0.0004 |
| Bud Neck | 0.0008 | 0.0004 | 0.0008 | 0.001 | 0.0029 | 0.0015 | 0.001 | 0.0003 | 0.0008 | 0.0008 | 0.0013 | 0.0012 | 0.0043 | 0.0002 | 0.0005 | 0.0026 | 0.0011 | 0.001 |
| Bud Periphery | 0.0011 | 0.0013 | 0.0008 | 0.0008 | 0.0015 | 0.0008 | 0.0013 | 0.0003 | 0.0007 | 0.0007 | 0.0018 | 0.0006 | 0.0009 | 0.0002 | 0.0004 | 0.0002 | 0.0117 | 0.0003 |
| Bud Site | 0.0018 | 0.0024 | 0.0036 | 0.0009 | 0.0015 | 0.0002 | 0.0042 | 0.0015 | 0.0034 | 0.0004 | 0.008 | 0.0002 | 0.0043 | 0.0018 | 0.0009 | 0.0006 | 0.0038 | 0.0001 |
| Cell Periphery | 0.0011 | 0.0011 | 0.0008 | 0.0002 | 0.0007 | 0.0004 | 0.0055 | 0.0002 | 0.0004 | 0.0002 | 0.0002 | 0.0002 | 0.0004 | 0.0002 | 0.0002 | 0.0001 | 0.0003 | 0.0001 |
| Cytoplasm | 0.6561 | 0.8896 | 0.7725 | 0.7223 | 0.6281 | 0.7579 | 0.5945 | 0.8988 | 0.7762 | 0.6673 | 0.694 | 0.7513 | 0.5746 | 0.8974 | 0.7764 | 0.8148 | 0.5732 | 0.8093 |
| Cytoplasmic Foci | 0.0338 | 0.0188 | 0.0206 | 0.0298 | 0.0484 | 0.0235 | 0.0462 | 0.0158 | 0.0317 | 0.0293 | 0.0478 | 0.0255 | 0.0546 | 0.0159 | 0.0291 | 0.0273 | 0.0402 | 0.0235 |
| Eisosomes | 0.0003 | 0 | 0 | 0 | 0.0006 | 0 | 0.0005 | 0 | 0 | 0 | 0.0001 | 0.0001 | 0.0007 | 0 | 0 | 0.0001 | 0.0001 | 0 |
| Endoplasmic Reticulum | 0.0942 | 0.0257 | 0.05 | 0.0242 | 0.0443 | 0.0615 | 0.0773 | 0.0197 | 0.034 | 0.1059 | 0.0572 | 0.0784 | 0.0543 | 0.0212 | 0.0514 | 0.012 | 0.0122 | 0.0332 |
| Endosome | 0.0867 | 0.0323 | 0.0821 | 0.1194 | 0.1457 | 0.0927 | 0.1178 | 0.0343 | 0.088 | 0.0938 | 0.0958 | 0.0864 | 0.1101 | 0.0393 | 0.0852 | 0.0765 | 0.2103 | 0.0844 |
| Golgi | 0.0196 | 0.0071 | 0.0131 | 0.0121 | 0.021 | 0.0178 | 0.0368 | 0.0089 | 0.0264 | 0.0287 | 0.0273 | 0.0208 | 0.0323 | 0.0076 | 0.0208 | 0.0075 | 0.0482 | 0.0223 |
| Lipid Particles | 0.0123 | 0.0001 | 0.0004 | 0.0013 | 0.0082 | 0.0001 | 0.0228 | 0.0001 | 0.0012 | 0.0126 | 0.0042 | 0.0008 | 0.0214 | 0.001 | 0.0005 | 0.0008 | 0.0029 | 0.0004 |
| Mitochondria | 0.0201 | 0.008 | 0.0227 | 0.007 | 0.025 | 0.0298 | 0.0346 | 0.0103 | 0.0148 | 0.0318 | 0.0394 | 0.0173 | 0.0558 | 0.0056 | 0.0125 | 0.0017 | 0.0276 | 0.016 |
| None | 0.0097 | 0.0016 | 0.0021 | 0.0009 | 0.0056 | 0.0014 | 0.0025 | 0.0007 | 0.001 | 0.0012 | 0.0009 | 0.0017 | 0.0041 | 0.001 | 0.0009 | 0.0016 | 0.0012 | 0.0008 |
| Nuclear Periphery | 0.0079 | 0.0016 | 0.0033 | 0.0013 | 0.0059 | 0.0013 | 0.0061 | 0.0006 | 0.0026 | 0.003 | 0.002 | 0.0015 | 0.0177 | 0.0016 | 0.0025 | 0.0014 | 0.0048 | 0.0011 |
| Nucleolus | 0.0004 | 0 | 0 | 0 | 0.0008 | 0 | 0.0004 | 0 | 0.0001 | 0 | 0.0002 | 0 | 0.0004 | 0.0001 | 0 | 0 | 0.0005 | 0 |
| Nucleus | 0.0019 | 0.0008 | 0.0012 | 0.0009 | 0.0026 | 0.0009 | 0.0017 | 0.0006 | 0.0009 | 0.0008 | 0.0011 | 0.0008 | 0.0075 | 0.0008 | 0.0008 | 0.0011 | 0.0044 | 0.0006 |
| Peroxisomes | 0.0112 | 0.0002 | 0.0001 | 0.0591 | 0.0243 | 0.0001 | 0.0102 | 0.0001 | 0.0013 | 0.0051 | 0.003 | 0.0004 | 0.0135 | 0.0002 | 0.0018 | 0.0014 | 0.0022 | 0.0001 |
| Punctate Nuclear | 0.0064 | 0.0001 | 0.0001 | 0.0001 | 0.0045 | 0.0001 | 0.0022 | 0.0001 | 0.0003 | 0.0003 | 0.0007 | 0.0004 | 0.0033 | 0.0003 | 0.0002 | 0.0017 | 0.0007 | 0.0001 |
| Vacuole | 0.0143 | 0.004 | 0.0176 | 0.0112 | 0.0108 | 0.0052 | 0.0112 | 0.0046 | 0.008 | 0.0087 | 0.0043 | 0.0035 | 0.0068 | 0.0023 | 0.0061 | 0.007 | 0.0115 | 0.0025 |
| Vacuole Periphery | 0.0039 | 0.0017 | 0.005 | 0.0045 | 0.0061 | 0.0029 | 0.0033 | 0.0011 | 0.0031 | 0.0038 | 0.0027 | 0.0025 | 0.0039 | 0.001 | 0.0027 | 0.0026 | 0.0077 | 0.0022 |
Sequencing Data
| R1 | R2 | |||||||||
|---|---|---|---|---|---|---|---|---|---|---|
| G1 Post-START | S/G2 | Metaphase | Anaphase | Telophase | G1 Post-START | S/G2 | Metaphase | Anaphase | Telophase | |
| Gene Expression | 76.3753 | 54.8674 | 53.8772 | 63.7242 | 75.9882 | 62.7269 | 72.5782 | 72.3519 | 70.3174 | 75.0762 |
| Translational Efficiency | 1.0616 | 1.28 | 1.3316 | 0.9903 | 1.058 | 1.4855 | 0.9779 | 1.0566 | 1.089 | 1.1015 |
Hit Data
| Dataset | Hit |
|---|---|
| Protein Concentration | ✘ |
| Protein Localization | ✘ |
| Gene Expression | ✘ |
| Translational Efficiency | ✘ |
Endocytosis
| Temp | Actin Patch (Sac6-tdTomato) | Cortical Patch (Sla1-GFP) | Late Endosome (Snf7-GFP) | Vacuole (Vph1-GFP) |
|---|---|---|---|---|
| 37℃ | ||||
| RT |
Cell Cycle Omics
CYCLoPs (Pat1-GFP)
| Gene / Allele | Actin Patch (Sac6-tdTomato) | Cortical Patch (Sla1-GFP) | Late Endosome (Snf7-GFP) | Vacuole (Sac6-tdTomato) |
|---|
| Gene | Images |
|---|
| Gene | Images |
|---|
Images are not yet available
Images are not yet available